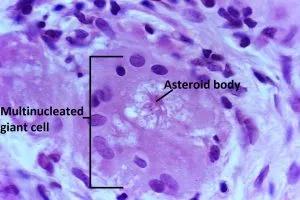
Asteroid body in multinucleated giant cell in sarcoidosis

Pathophysiology - Granulomas Gone Wild
- Trigger: Unknown inhaled antigen in genetically susceptible individuals.
- Core Defect: Exaggerated, cell-mediated immune response driven by CD4+ Th1 cells.
- Mechanism: Antigen-presenting cells (APCs) activate CD4+ T-cells, leading to a cytokine cascade (↑ IL-2, ↑ IFN-γ, ↑ TNF-α).
- This recruits and activates macrophages, which differentiate into epithelioid cells and multinucleated giant cells, forming the hallmark non-caseating granulomas.
⭐ High-Yield: Bronchoalveolar lavage (BAL) fluid characteristically shows a CD4/CD8 ratio > 3.5, reflecting the intense T-helper cell activity in the lungs.
Clinical Features - The Great Masquerader
- General: Often asymptomatic (incidental CXR finding). Can present with fever, weight loss, fatigue.
- Pulmonary (~90%): Dry cough, dyspnea, chest pain. The most common presentation.
- Classic finding: Bilateral hilar lymphadenopathy (BHL).
- Skin (25%):
- Erythema Nodosum: Painful red nodules on shins; associated with acute disease & good prognosis.
- Lupus Pernio: Violaceous plaques on nose, cheeks, ears; specific for chronic sarcoidosis.
- Papules, nodules, plaques.
- Ocular (~25%): Anterior uveitis is most common; posterior uveitis, conjunctivitis, dry eyes.
- Cardiac: Arrhythmias (heart block), cardiomyopathy, sudden death.
- Neurologic: Cranial nerve palsies (esp. CN VII), aseptic meningitis.
⭐ Löfgren's Syndrome: An acute, high-prognosis triad of fever, bilateral hilar lymphadenopathy, and erythema nodosum/polyarthritis.
Diagnostics - Cracking the Case
-
Initial Labs:
- ↑ Serum Angiotensin-Converting Enzyme (ACE) levels (in >75% of patients)
- ↑ Serum calcium (hypercalcemia) due to granulomatous production of $1,25-(OH)_2D_3$
- Pancytopenia on CBC
-
Imaging:
- Chest X-Ray: The cornerstone. Bilateral hilar lymphadenopathy is the classic finding.
- Gallium-67 Scan: Panda sign (lacrimal/salivary glands) & Lambda sign (hilar/paratracheal nodes).
-
Definitive Diagnosis:
- Biopsy: Transbronchial biopsy is the preferred method. Shows non-caseating granulomas.
⭐ Löfgren's Syndrome: An acute, highly specific form of sarcoidosis presenting with fever, bilateral hilar lymphadenopathy, and erythema nodosum. Excellent prognosis.
Management - Taming Inflammation
- Asymptomatic/Stage I: Observation; high rate of spontaneous remission.
- Symptomatic Disease: Oral corticosteroids are first-line.
- Indicated for worsening respiratory symptoms, cardiac, neuro, or ocular disease, or severe hypercalcemia.
- Start prednisone 20-40 mg/day for 4-6 weeks, then slow taper.
- Steroid-Sparing Agents: For refractory cases or to limit steroid toxicity.
- Methotrexate (most common), azathioprine, leflunomide.
⭐ Infliximab, a TNF-α inhibitor, is reserved for severe, refractory sarcoidosis, especially neurosarcoidosis.
High-Yield Points - ⚡ Biggest Takeaways
- Non-caseating granulomas are the pathognomonic finding on biopsy, essential for diagnosis.
- Classic chest imaging reveals bilateral hilar lymphadenopathy and pulmonary reticular opacities.
- Expect elevated serum ACE levels and hypercalcemia from extra-renal vitamin D activation by macrophages.
- Key extrapulmonary signs include erythema nodosum, lupus pernio, and anterior uveitis.
- Asymptomatic patients are often monitored; systemic corticosteroids are first-line for symptomatic disease.
Unlock the full lesson and continue reading
Signup to continue reading this lesson and unlimited access questions, flashcards, AI notes, and more